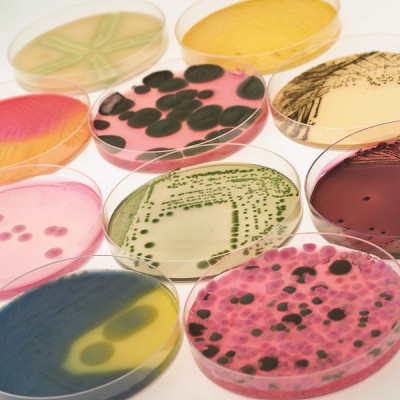

Farmaceutické laboratórium vykonáva skúšky kvality, účinnosti a/ alebo akosti surovín, medziproduktov a finálnych výrobkov pre farmaceutický priemysel. Vďaka naším vysoko kvalifikovaným a skúseným pracovníkom, moderným analytickým prístrojom a systémom, môžeme požiadavky spracovávať rýchlo a efektívne. Presnosť a správnosť výsledkov je vždy našou najvyššou prioritou.

- Stanovenie obsahu účinnej látky
- Stanovenie obsahu pomocnej látky
- Identifikácia
- Stanovenie obsahu nečistôt
- Disolučné profily
- Dezintegrácia
- Rozmery a tvrdosť pevných liekových foriem
- pH
- Konduktivita
- Strata žíhaním v sušiarni
- Strata žíhaním
|
- Síranový popol
- Obsah vody
- Identifikácia metódou FTIR
- UV/VIS spektroskopické parametre
- Optická otáčavosť
- Špecifická optická otáčavosť
- Index lomu
- Vzhľad a farba roztokov
- Obsah kovov
- Celkový organický uhlík
- Obsah zbytkových rozpúšťadiel
|

- Identifikácia metódou tenkovrstvovej chromatografie
- Sieťová analýza
- Stanovenie obsahu titračne
- Vzhľad
- Hustota
- Iónové zrážacie reakcie

- Celkový počet aeróbnych mikroorganizmov
- Celkový počet kvasiniek/plesní
- Bakteriálne endotoxíny
- Clostridium perfringens
- Escherichia coli
- Žlč-tolerujúce gramnegatívne baktérie
|
- Pseudomonas aeruginosa
- Salmonella spp.
- Staphylococcus aureus
- Celkový počet baktérií
- Celkový počet húb
- Celkový počet životaschopných mikroorganizmov
|
- Kyslo a zásadito reagujúce látky
- Chloridy, sírany, amoniak
- Ťažké kovy
- Dusičnany
- Oxidovateľné látky
- Vápník a horčík
- Zbytok po odparení
- Konduktivita
|
- Fluoridy
- Vzhľad
- Celkový organický uhlík
- Celkový voľný chlór
- pH
- Celkový počet životaschopných mikroorganizmov
- Bakteriálne endotoxíny
- Kovy: Al, Ca, Mg, Hg, K, Na, Zn
|
Viace o rozborech vody tu.